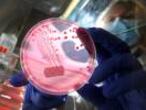

Somos microbios
Dependemos de las bacterias para nuestro correcto desarrollo y mantenimiento de la salud. Hoy se celebra por primera vez el Día Mundial del Microbioma

Este miércoles, 27 de junio, se celebra por primera vez el Día Mundial del Microbioma (#WorldMicrobiomeDay) bajo el lema "Piensa en tus microbios".
A pesar de que desde hace siglos se conocía que los animales -incluido el ser humano- eran portadores de muchos microorganismos, apenas se les prestó atención. Hasta que, ya en los últimos años y gracias a las nuevas técnicas de secuenciación masiva que nos permiten estudiar las comunidades microbianas sin necesidad de cultivarlas, se ha constatado que en realidad dependemos de ellos para nuestro correcto desarrollo y mantenimiento de la salud.
Podríamos definir la microbiota como el conjunto de microorganismos (bacterias, arqueas, virus, hongos y protistas) que residen en nuestro cuerpo. A veces se confunde con el término microbioma, que es mucho más amplio y hace referencia al conjunto de esas comunidades microbianas, incluyendo sus genes y las sustancias químicas que producen, así como las condiciones ambientales que les rodean. Estos ecosistemas microbianos se encuentran en el tracto gastrointestinal, genitourinario y respiratorio, la cavidad oral y nasofaríngea, y la piel.
Durante mucho tiempo se llegó a pensar que el 90% de nuestras células eran bacterias. Los últimos cálculos, en cambio, sitúan este porcentaje en un 50%. Puede parecer poco, pero el hecho de poseer la misma cantidad de bacterias que de células humanas es como afirmar que somos "mitad humano, mitad bacteria". El ser humano, por lo tanto, no es una unidad independiente, sino una comunidad dinámica e interactiva de células humanas y microbianas. Una especie de "superorganismo".
También en las últimas décadas hemos confirmado que la diversidad de microbios de nuestro organismo es enorme, y que la composición difiere en cada persona, con muchos factores que influyen en su evolución. Se estima que en un cuerpo sano habitan más de 10.000 especies bacterianas diferentes, de las cuales menos del 1% corresponderían a potenciales patógenos. En general, nuestras comunidades microbianas se componen de algunos tipos bacterianos (muy pocos) muy abundantes y frecuentes, junto con muchas bacterias distintas pero representadas en pequeño número.
Además, el conjunto de microbios de nuestro cuerpo evoluciona a lo largo de la vida. Conforme vamos creciendo, nuestra microbiota va cambiando: mientras que en los bebés el conjunto es bastante uniforme –pero su diversidad microbiana es baja, muy inestable y susceptible a los cambios-, a medida que los niños crecen sus microorganismos maduran y se diversifican, hasta llegar a la edad adulta. Entonces la microbiota se vuelve cada vez más diversa, estable y difícil de modificar. En la tercera edad, por último, el número de especies microbianas disminuye y el conjunto se hace similar entre individuos. No obstante, las especies que albergamos (y el número de ellas) no solo cambian con la edad, sino que se ven influenciadas según seamos hombre o mujer, por nuestra genética, el tipo de dieta, el clima y la localización geográfica; así como por la exposición a fármacos, los tratamientos con antibióticos, la ocupación o la interacción con otros individuos.
El análisis de la microbiota: un cambio de paradigma en la medicina personalizada
Los dos campos donde existe mayor evidencia del papel de la microbiota serían la Nutrición y la Inmunología. Por un lado, los microbios intestinales degradan sales biliares, proteínas y polisacáridos, con el objetivo de producir vitaminas y otros cofactores esenciales para nuestra salud. Al mismo tiempo, estimulan y activan nuestras defensas naturales, mantienen la barrera intestinal y evitan la colonización de microorganismos patógenos. También aumentan las evidencias (aunque son estudios más preliminares) que relacionan la microbiota con distintas patologías, como la enfermedad inflamatoria intestinal, enfermedades metabólicas, alergias, asma y enfermedades del sistema nervioso central (depresión, autismo) o neurodegenerativas (Alzheimer, Parkinson, esclerosis múltiple), e incluso con el cáncer.
Así, parece claro que en un futuro próximo el análisis del microbioma humano se incorporará a los protocolos de la medicina personalizada de precisión. El resultado será un tratamiento para cada persona en función de los datos del genoma, del metabolismo, de su sistema inmune y también de su microbioma. A partir de la composición de la microbiota se podrán identificar microorganismos oportunistas potencialmente patógenos, posibles deficiencias e incluso su interacción con el tratamiento propuesto. Mientras este avance llega, te recomiendo pensar (y mucho) en tus microbios, porque de su buen estado dependerá el tuyo.
Ignacio López-Goñi (@microbioblog) es catedrático de Microbiología de la Universidad de Navarra y autor de Microbiota: los microbios de tu organismo (Editorial Almuzara).
Tu suscripción se está usando en otro dispositivo
¿Quieres añadir otro usuario a tu suscripción?
Si continúas leyendo en este dispositivo, no se podrá leer en el otro.
FlechaTu suscripción se está usando en otro dispositivo y solo puedes acceder a EL PAÍS desde un dispositivo a la vez.
Si quieres compartir tu cuenta, cambia tu suscripción a la modalidad Premium, así podrás añadir otro usuario. Cada uno accederá con su propia cuenta de email, lo que os permitirá personalizar vuestra experiencia en EL PAÍS.
¿Tienes una suscripción de empresa? Accede aquí para contratar más cuentas.
En el caso de no saber quién está usando tu cuenta, te recomendamos cambiar tu contraseña aquí.
Si decides continuar compartiendo tu cuenta, este mensaje se mostrará en tu dispositivo y en el de la otra persona que está usando tu cuenta de forma indefinida, afectando a tu experiencia de lectura. Puedes consultar aquí los términos y condiciones de la suscripción digital.
Más información
Archivado En
Últimas noticias
La Comunidad de Madrid aprueba la jornada partida en los colegios: contenta a los padres e indigna a los profesores
La Asamblea francesa aprueba la prórroga presupuestaria pero no evita el bloqueo
Endrick, cedido al Olympique de Lyon hasta final de temporada
La Audiencia de Valencia avala la negativa de la jueza de la dana a investigar al presidente de la Confederación del Júcar
Lo más visto
- Lotería de Navidad 2025 | 79432, el primer premio de la Lotería de Navidad
- Comprobar Lotería de Navidad 2025: consulta la pedrea con la lista de números premiados
- El Gobierno y Bildu acuerdan extender a 2026 la prohibición de desahuciar a personas vulnerables
- El PP de Almeida vota en contra de dedicarle a Robe Iniesta un centro juvenil porque antes quiere hablarlo con su familia
- Europa presiona a Ucrania para que contenga el éxodo de jóvenes hacia los países vecinos